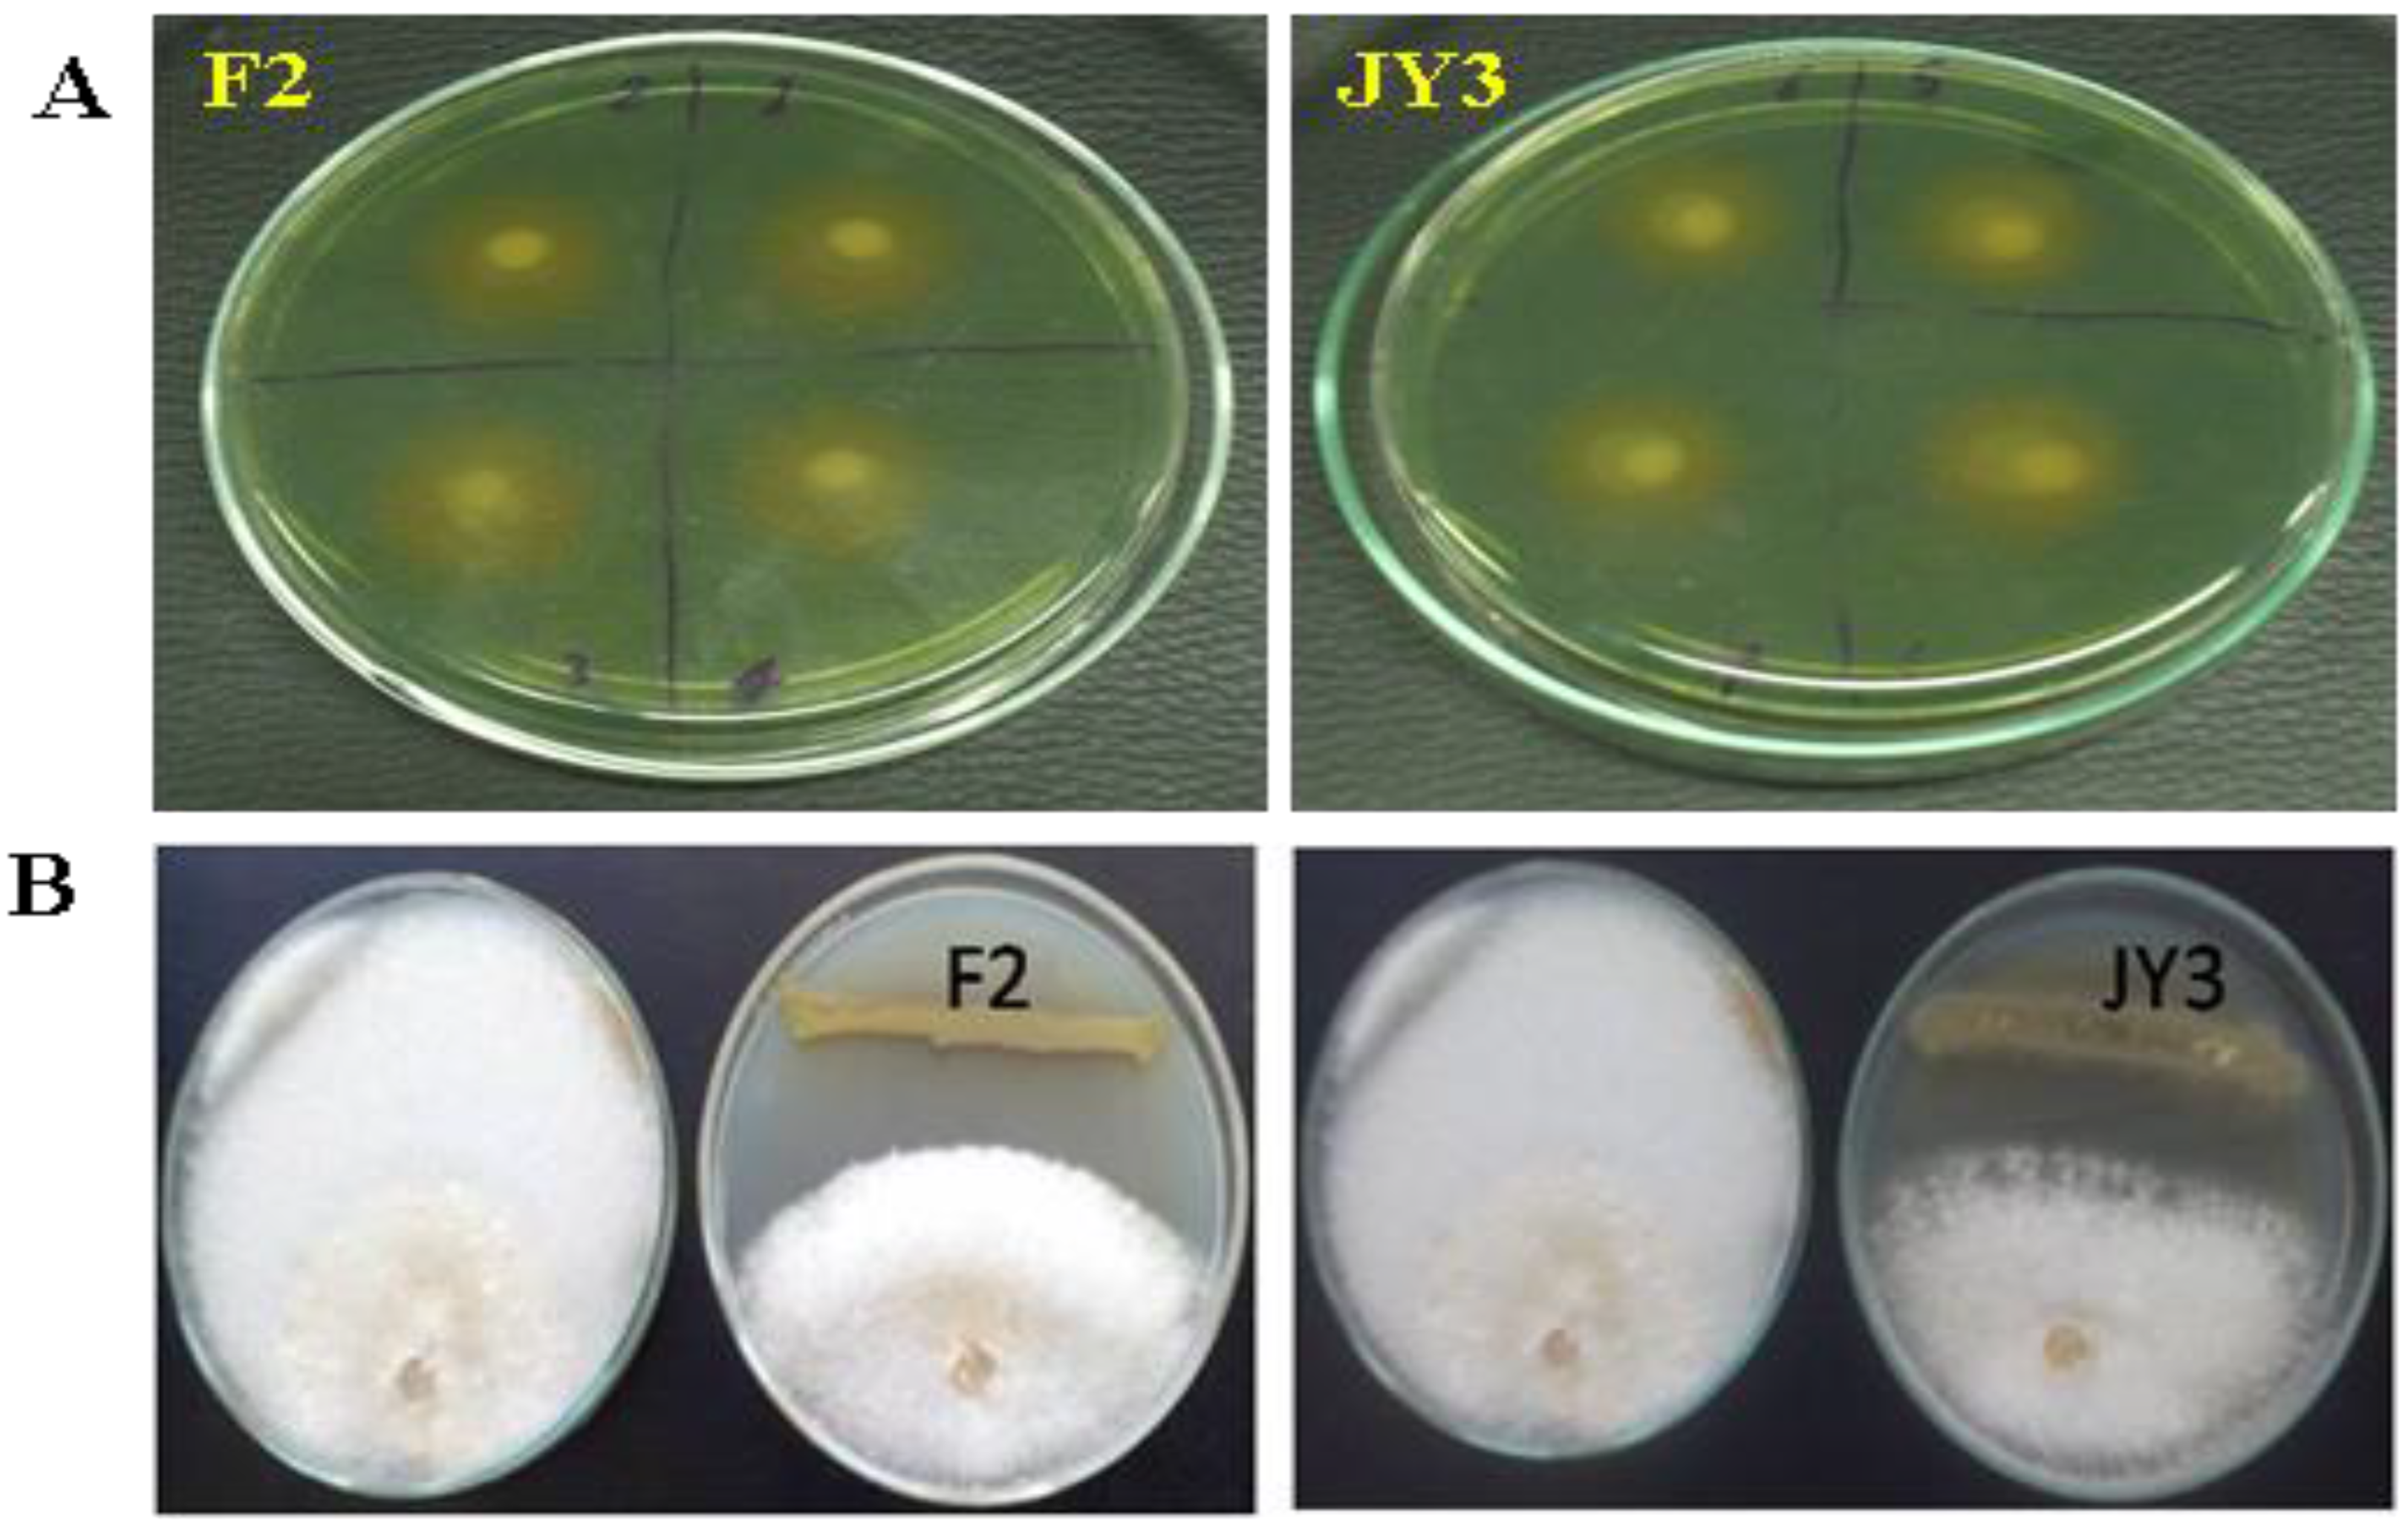

Evaluation of Bio-Friendly Formulations from Siderophore-Producing Fluorescent Pseudomonas as Biocontrol Agents for the Management of Soil-Borne Fungi, Fusarium oxysporum and Rhizoctonia solani
Abstract
1. Introduction
2. Materials and Methods
2.1. Source of Bacterial and Fungal Isolates
2.2. Chrome Azurol S (CAS) Agar Plates for Detection of Siderophores Production
2.3. Antagonistic Activity of P. fluorescens JY3 and P. aeruginosa F2 (In Vitro)
2.4. Batch Fermentation in Shake Flask
2.5. Analytical Procedures
2.5.1. Siderophores Estimation
2.5.2. Biomass Estimation
2.5.3. Glucose Estimation
2.5.4. Glycerol Estimation
2.6. Pseudomonas Isolates Producing Siderophores as Biocontrol Agents
2.6.1. Formulation Experiment
2.6.2. Preparation of Fungal Inoculum
2.6.3. Soil Infestation
2.6.4. Greenhouse Experiment
3. Results
3.1. Detection of Siderophore Production on CAS Agar Plates
3.2. Antagonistic Activity of P. fluorescens JY3 and P. aeruginosa F2
3.3. Batch Fermentation in a Shake Flask
3.4. Efficacy Evaluation of F2 and JY3 Formulations under Greenhouse Conditions
4. Discussion
5. Conclusions
Author Contributions
Funding
Institutional Review Board Statement
Data Availability Statement
Acknowledgments
Conflicts of Interest
References
- Redda, E.T.; Ma, J.; Mei, J.; Li, M.; Wu, B.; Jiang, X. Antagonistic potential of different isolates of Trichoderma against Fusarium oxysporum, Rhizoctonia solani, and Botrytis cinerea. Eur. J. Exp. Biol. 2018, 8, 12. [Google Scholar]
- Abd El-Rahim, W.M.; Mostafa, E.M.; Moawad, H. High cell density cultivation of six fungal strains efficient in azo dye bioremediation. Biotechnol. Rep. 2016, 12, 1–5. [Google Scholar] [CrossRef] [PubMed]
- Emmert, E.A.B.; Handelsman, J. Biocontrol of plant disease: A (Gram-) positive perspective. FEMS Microbiol. Lett. 1999, 171, 1–9. [Google Scholar] [CrossRef]
- Abdel-Gayed, M.A.; Abo-Zaid, G.A.; Mohamed, M.S.; Elsayed, H.E. Fermentation, formulation and evaluation of PGPR Bacillus subtilis isolate as a bioagent for reducing occurrence of peanut soil-borne diseases. J. Integr. Agric. 2019, 18, 2080–2092. [Google Scholar]
- Lo, C.-T. General mechanisms of action of microbial biocontrol agents. Plant Pathol. Bull. 1998, 7, 155–166. [Google Scholar]
- Abo-Zaid, G.; Abdelkhalek, A.; Matar, S.; Darwish, M.; Abdel-Gayed, M. Application of Bio-Friendly Formulations of Chitinase-Producing Streptomyces cellulosae Actino 48 for Controlling Peanut Soil-Borne Diseases Caused by Sclerotium rolfsii. J. Fungi 2021, 7, 167. [Google Scholar] [CrossRef]
- Weller, D.M. Pseudomonas biocontrol agents of soilborne pathogens: Looking back over 30 years. Phytopathology 2007, 97, 250–256. [Google Scholar] [CrossRef]
- Shanmugaiah, V.; Nithya, K.; Harikrishnan, H.; Jayaprakashvel, M.; Balasubramanian, N. Biocontrol mechanisms of siderophores against bacterial plant pathogens. In Sustainable Approaches to Controlling Plant Pathogenic Bacteria; CRC Press: Boca Raton, FL, USA, 2015; pp. 167–190. [Google Scholar]
- Ngamau, C.; Matiru, V.N.; Tani, A.; Muthuri, C. Potential use of endophytic bacteria as biofertilizer for sustainable banana (Musa spp.) production. Afr. J. Hortic. Sci. 2014, 8, 1–11. [Google Scholar]
- Kloepper, J.W.; Leong, J.; Teintze, M.; Schroth, M.N. Enhanced plant growth by siderophores produced by plant growth-promoting rhizobacteria. Nature 1980, 286, 885–886. [Google Scholar] [CrossRef]
- Arya, N.; Rana, A.; Rajwar, A.; Sahgal, M.; Sharma, A.K. Biocontrol efficacy of siderophore producing indigenous Pseudomonas strains against Fusarium Wilt in Tomato. Natl. Acad. Sci. Lett. 2018, 41, 133–136. [Google Scholar] [CrossRef]
- Park, C.-S.; Paulitz, T.C.; Baker, R. Biocontrol of Fusarium wilt of cucumber resulting from interactions between Pseudomonas putida and nonpathogenic isolates of Fusarium oxysporum. Phytopathology 1988, 78, 190–194. [Google Scholar] [CrossRef]
- Barbhaiya, H.B.; Rao, K.K. Production of pyoverdine, the fluorescent pigment of Pseudomonas aeruginosa PAO1. FEMS Microbiol. Lett. 1985, 27, 233–235. [Google Scholar] [CrossRef]
- Greppin, H.; Gouda, S. Action de la lumiere sur le pigment de Pseudomonas fluorescens Migula. Arch. Sci. 1965, 18, 721–725. [Google Scholar]
- Lenhoff, H. An inverse relationship of the effects of oxygen and iron on the production of fluorescin and cytochrome c by Pseudomonas fluorescens. Nature 1963, 199, 601–602. [Google Scholar] [CrossRef] [PubMed]
- Weisbeek, P.J.; Van der Hofstad, G.; Schippers, B.; Marugg, J.D. Genetic analysis of the iron-uptake system of two plant groups promoting Pseudomonas strains. In Siderophores, and Plant Diseases; Springer: Boston, MA, USA, 1986; pp. 299–313. [Google Scholar]
- Georgia, F.R.; Poe, C.F. Study of Bacterial fluorescence in various media: I. Inorganic substances necessary for bacterial fluorescence. J. Bacteriol. 1931, 22, 349–361. [Google Scholar] [CrossRef] [PubMed]
- Chakrabarty, A.M.; Roy, S.C. Effect of trace elements on the production of pigments by a pseudomonad. Biochem. J. 1964, 93, 228. [Google Scholar] [CrossRef] [PubMed]
- Masalha, J.; Kosegarten, H.; Elmaci, Ö.; Mengel, K. The central role of microbial activity for iron acquisition in maize and sunflower. Biol. Fertil. Soils 2000, 30, 433–439. [Google Scholar] [CrossRef]
- Katiyar, V.; Goel, R. Siderophore mediated plant growth promotion at low temperature by mutant of fluorescent pseudomonad⋆. Plant Growth Regul. 2004, 42, 239–244. [Google Scholar] [CrossRef]
- Dimkpa, C.O.; Merten, D.; Svatoš, A.; Büchel, G.; Kothe, E. Metal-induced oxidative stress impacting plant growth in contaminated soil is alleviated by microbial siderophores. Soil Biol. Biochem. 2009, 41, 154–162. [Google Scholar] [CrossRef]
- Burd, G.I.; Dixon, D.G.; Glick, B.R. A plant growth-promoting bacterium that decreases nickel toxicity in seedlings. Appl. Environ. Microbiol. 1998, 64, 3663–3668. [Google Scholar] [CrossRef]
- Dimkpa, C.; Svatoš, A.; Merten, D.; Büchel, G.; Kothe, E. Hydroxamate siderophores produced by Streptomyces acidiscabies E13 bind nickel and promote growth in cowpea (Vigna unguiculata L.) under nickel stress. Can. J. Microbiol. 2008, 54, 163–172. [Google Scholar] [CrossRef] [PubMed]
- Haas, D.; Défago, G. Biological control of soil-borne pathogens by fluorescent pseudomonads. Nat. Rev. Microbiol. 2005, 3, 307–319. [Google Scholar] [CrossRef] [PubMed]
- Sahu, G.K.; Sindhu, S.S. Disease control and plant growth promotion of green gram by siderophore producing Pseudomonas sp. Res. J. Microbiol. 2011, 6, 735. [Google Scholar]
- Couillerot, O.; Prigent-Combaret, C.; Caballero-Mellado, J.; Moënne-Loccoz, Y. Pseudomonas fluorescens and closely-related fluorescent pseudomonads as biocontrol agents of soil-borne phytopathogens. Lett. Appl. Microbiol. 2009, 48, 505–512. [Google Scholar] [CrossRef]
- Wensing, A.; Braun, S.D.; Büttner, P.; Expert, D.; Völksch, B.; Ullrich, M.S.; Weingart, H. Impact of siderophore production by Pseudomonas syringae pv. syringae 22d/93 on epiphytic fitness and biocontrol activity against Pseudomonas syringae pv. glycinea 1a/96. Appl. Environ. Microbiol. 2010, 76, 2704–2711. [Google Scholar] [CrossRef]
- Wang, H.; Liu, R.; You, M.P.; Barbetti, M.J.; Chen, Y. Pathogen biocontrol using plant growth-promoting bacteria (PGPR): Role of bacterial diversity. Microorganisms 2021, 9, 1988. [Google Scholar] [CrossRef] [PubMed]
- Schwyn, B.; Neilands, J.B. Universal chemical assay for the detection and determination of siderophores. Anal. Biochem. 1987, 160, 47–56. [Google Scholar] [CrossRef]
- Touré, Y.; Ongena, M.; Jacques, P.; Guiro, A.; Thonart, P. Role of lipopeptides produced by Bacillus subtilis GA1 in the reduction of grey mould disease caused by Botrytis cinerea on apple. J. Appl. Microbiol. 2004, 96, 1151–1160. [Google Scholar] [CrossRef]
- Abo-Zaid, G.A.; Abdullah, A.S.; Soliman, N.A.-M.; El-Sharouny, E.E.; Sabry, S.A.-F. Optimization of siderophores production from fluorescent pseudomonads using statistical experimental designs. Biosci. Res. 2018, 15, 3040–3051. [Google Scholar]
- Van Dam-Mieras, M.C.E.; Jeu, W.H.; Vries, J.; Currell, B.R.; James, J.W.; Leach, C.K.; Patmore, R.A. Techniques Used in Bioproduct Analysis; Butterworth-Heinemann: Oxford, UK, 1992. [Google Scholar]
- Bok, S.H.; Demain, A.L. An improved colorimetric assay for polyols. Anal. Biochem. 1977, 81, 18–20. [Google Scholar] [CrossRef]
- Hussien, Z.N.; Mahmoud, E.Y.; Metwaly, A.H.; Sobhy, H.M. Effect of some antagonistic bacteria in reducing of peanut damping-off, root and pod rot incidence caused by Rhizoctonia solani. J. Plant Prot. Pathol. 2012, 3, 1173–1187. [Google Scholar] [CrossRef]
- Sasirekha, B.; Srividya, S. Siderophore production by Pseudomonas aeruginosa FP6, a biocontrol strain for Rhizoctonia solani and Colletotrichum gloeosporioides causing diseases in chilli. Agric. Nat. Resour. 2016, 50, 250–256. [Google Scholar] [CrossRef]
- Yu, S.; Teng, C.; Liang, J.; Song, T.; Dong, L.; Bai, X.; Jin, Y.; Qu, J. Characterization of siderophore produced by Pseudomonas syringae BAF. 1 and its inhibitory effects on spore germination and mycelium morphology of Fusarium oxysporum. J. Microbiol. 2017, 55, 877–884. [Google Scholar] [CrossRef]
- Reddy, B.P.; R, J.; Reddy, M.S.; Kumar, K. Siderophore isolation and its biocontrol action against rice fungal pathogens. Biochem. Mol. Biol. 2019, 1, 1–6. [Google Scholar]
- Mathiyazhagan, S.; Kavitha, K.; Nakkeeran, S.; Chandrasekar, G.; Manian, K.; Renukadevi, P.; Krishnamoorthy, A.S.; Fernando, W.G.D. PGPR mediated management of stem blight of Phyllanthus amarus (Schum and Thonn) caused by Corynespora cassiicola (Berk and Curt) Wei. Arch. Phytopathol. Plant Prot. 2004, 37, 183–199. [Google Scholar] [CrossRef]
- Santos, S.; Neto, I.F.F.; Machado, M.D.; Soares, H.M.V.M.; Soares, E.V. Siderophore production by Bacillus megaterium: Effect of growth phase and cultural conditions. Appl. Biochem. Biotechnol. 2014, 172, 549–560. [Google Scholar] [CrossRef]
- Buyer, J.S.; Leong, J. Iron transport-mediated antagonism between plant growth-promoting and plant-deleterious Pseudomonas strains. J. Biol. Chem. 1986, 261, 791–794. [Google Scholar] [CrossRef]
- Leeman, M.; Den Ouden, F.M.; Van Pelt, J.A.; Dirkx, F.P.M.; Steijl, H.; Bakker, P.; Schippers, B. Iron availability affects induction of systemic resistance to Fusarium wilt of radish by Pseudomonas fluorescens. Phytopathology 1996, 86, 149–155. [Google Scholar] [CrossRef]
- Sharma, A.; Johri, B.N.; Sharma, A.K.; Glick, B.R. Plant growth-promoting bacterium Pseudomonas sp. strain GRP3 influences iron acquisition in mung bean (Vigna radiata L. Wilzeck). Soil Biol. Biochem. 2003, 35, 887–894. [Google Scholar] [CrossRef]

| Treatment | Damping-Off (%) | ** F. oxysporum Reduction (%) | ** R. solani Reduction (%) |
|---|---|---|---|
| F. oxysporum (Check) | 33.33 * ab | 0 | ___ |
| R. solani (Check) | 53.33 a | ___ | 0 |
| Control | 20 bc | 40 | 62.50 |
| F2 formulation | 0 c | 100 | 100 |
| JY3 formulation | 13.33 bc | 60.01 | 75 |
| F2 + F. oxysporum | 20 bc | 40 | ___ |
| JY3 + F. oxysporum | 6.67 bc | 80 | ___ |
| F2 + R. solani | 6.67 bc | ___ | 87.50 |
| JY3 + R. solani | 20 bc | ___ | 62.50 |
| L.S.D | 29.53 |
| Treatment | Fresh Weight of Shoots (g) | ** Increase (%) | ** Increase (%) | Fresh Weight of Roots (g) | ** Increase (%) | ** Increase (%) |
|---|---|---|---|---|---|---|
| F. oxysporum (Check) | 2.07 * c | 0 | ___ | 1.67 c | 0 | ___ |
| R. solani (Check) | 0.97 d | ___ | 0 | 0.60 d | ___ | 0 |
| Control | 3.63 ab | 42.98 | 73.28 | 3.23 ab | 48.30 | 81.42 |
| F2 formulation | 4.07 a | 49.14 | 76.17 | 3.71 a | 54.99 | 83.83 |
| JY3 formulation | 3.83 ab | 45.95 | 74.47 | 3.5 ab | 52.29 | 82.86 |
| F2 + F. oxysporum | 3.73 ab | 44.50 | ___ | 3.30 ab | 49.39 | ___ |
| JY3 + F. oxysporum | 3.80 ab | 45.53 | ___ | 3.47 ab | 51.87 | ___ |
| F2 + R. solani | 3.53 ab | ___ | 72.52 | 3.20 ab | ___ | 81.25 |
| JY3 + R. solani | 3.23 b | ___ | 69.97 | 2.87 b | ___ | 79.09 |
| L.S.D | 0.65 | 0.67 |
| Treatment | Dry Weight of Shoots (g) | ** Increase (%) | ** Increase (%) | Dry Weight of Roots (g) | ** Increase (%) | ** Increase (%) |
|---|---|---|---|---|---|---|
| F. oxysporum (Check) | 1.03 * d | 0 | ___ | 1.03 c | 0 | ___ |
| R. solani (Check) | 0.33 e | ___ | 0 | 0.18 d | ___ | 0 |
| Control | 2.67 abc | 61.42 | 87.64 | 2.1 b | 50.95 | 91.43 |
| F2 formulation | 3.17 a | 67.51 | 89.59 | 2.71 a | 61.99 | 93.36 |
| JY3 formulation | 2.93 ab | 64.85 | 88.74 | 2.37 ab | 56.54 | 92.41 |
| F2 + F. oxysporum | 2.73 abc | 62.27 | ___ | 2.37 ab | 56.54 | ___ |
| JY3 + F. oxysporum | 2.83 abc | 63.60 | ___ | 2.33 ab | 55.79 | ___ |
| F2 + R. solani | 2.5 bc | ___ | 86.80 | 2.03 b | ___ | 91.13 |
| JY3 + R. solani | 2.33 c | ___ | 85.84 | 1.83 b | ___ | 90.16 |
| L.S.D | 0.53 | 0.57 |
Disclaimer/Publisher’s Note: The statements, opinions and data contained in all publications are solely those of the individual author(s) and contributor(s) and not of MDPI and/or the editor(s). MDPI and/or the editor(s) disclaim responsibility for any injury to people or property resulting from any ideas, methods, instructions or products referred to in the content. |
© 2023 by the authors. Licensee MDPI, Basel, Switzerland. This article is an open access article distributed under the terms and conditions of the Creative Commons Attribution (CC BY) license (https://creativecommons.org/licenses/by/4.0/).
Share and Cite
Abo-Zaid, G.A.; Abdullah, A.S.; Soliman, N.A.-M.; El-Sharouny, E.E.; Al-Askar, A.A.; Su, Y.; Abdelkhalek, A.; Sabry, S.A.-F. Evaluation of Bio-Friendly Formulations from Siderophore-Producing Fluorescent Pseudomonas as Biocontrol Agents for the Management of Soil-Borne Fungi, Fusarium oxysporum and Rhizoctonia solani. Agriculture 2023, 13, 1418. https://doi.org/10.3390/agriculture13071418
Abo-Zaid GA, Abdullah AS, Soliman NA-M, El-Sharouny EE, Al-Askar AA, Su Y, Abdelkhalek A, Sabry SA-F. Evaluation of Bio-Friendly Formulations from Siderophore-Producing Fluorescent Pseudomonas as Biocontrol Agents for the Management of Soil-Borne Fungi, Fusarium oxysporum and Rhizoctonia solani. Agriculture. 2023; 13(7):1418. https://doi.org/10.3390/agriculture13071418
Chicago/Turabian StyleAbo-Zaid, Gaber Attia, Ahmed Salah Abdullah, Nadia Abdel-Mohsen Soliman, Ebaa Ebrahim El-Sharouny, Abdulaziz A. Al-Askar, Yiming Su, Ahmed Abdelkhalek, and Soraya Abdel-Fattah Sabry. 2023. "Evaluation of Bio-Friendly Formulations from Siderophore-Producing Fluorescent Pseudomonas as Biocontrol Agents for the Management of Soil-Borne Fungi, Fusarium oxysporum and Rhizoctonia solani" Agriculture 13, no. 7: 1418. https://doi.org/10.3390/agriculture13071418
APA StyleAbo-Zaid, G. A., Abdullah, A. S., Soliman, N. A.-M., El-Sharouny, E. E., Al-Askar, A. A., Su, Y., Abdelkhalek, A., & Sabry, S. A.-F. (2023). Evaluation of Bio-Friendly Formulations from Siderophore-Producing Fluorescent Pseudomonas as Biocontrol Agents for the Management of Soil-Borne Fungi, Fusarium oxysporum and Rhizoctonia solani. Agriculture, 13(7), 1418. https://doi.org/10.3390/agriculture13071418

